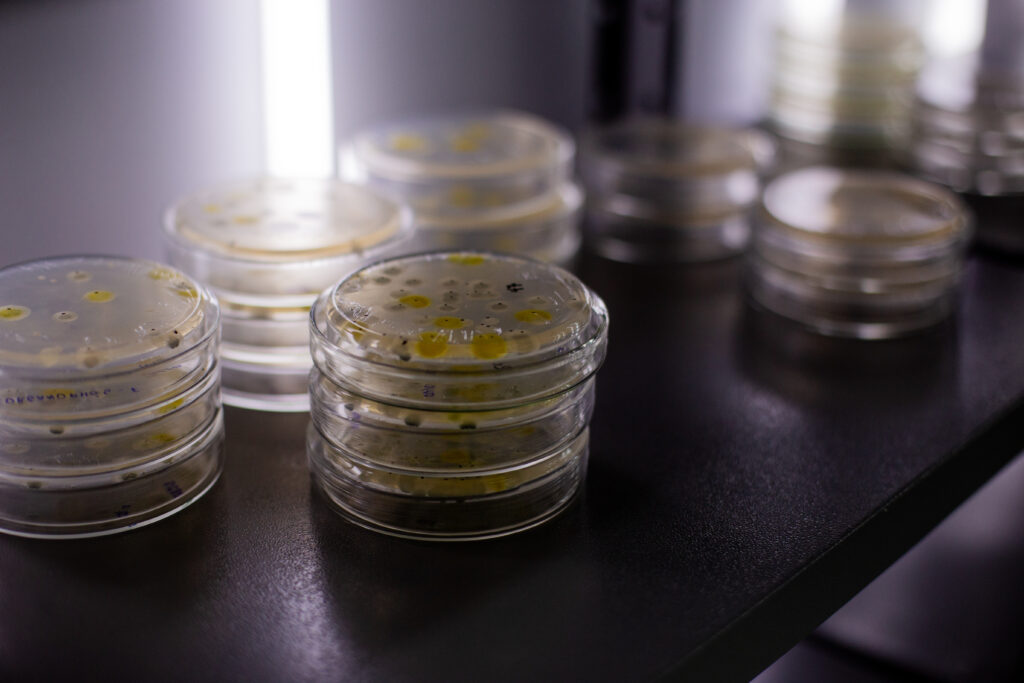

Coleções biológicas são acervos biológicos que abrigam conjuntos de representantes de organismos vivos ou fósseis (podendo ser exemplares completos ou somente parte deles) devidamente preservados e catalogados com a finalidade de estudos didáticos e científicos. As coleções biológicas são uma importante fonte de informação sobre a composição, distribuição espaço-temporal e conteúdo da biodiversidade em um determinado ambiente. Além disso, organizam e classificam os organismos sendo o ponto de partida para qualquer estudo relacionado com a biologia, ecologia, monitoramento ambiental, entre outros.
Como conjunto de informações cumulativo gerado ao longo do tempo, as coleções biológicas de microrganismos com fins de bioprospecção representam o potencial territorial em desenvolver insumos biológicos que sejam utilizados como biocontroladores, biofertilizantes e biorremediadores. Além disso, uma coleção biológica com microrganismos devidamente documentados, caracterizados, puros e viáveis, seguindo as normas do MAPA, IBAMA e da ANVISA, viabiliza uma bioprospecção sustentável, com potencial para descobrir e produzir novos bioinsumos de forma eficiente, rápida e responsável.
A Coleção Biológica Rosa de Oliveira (CBRO) nasce para fortalecer o compromisso com a inovação na pesquisa científica, garantindo os melhores produtos do mercado aos seus clientes ao reforçar a rastreabilidade e aumentar a segurança na qualidade dos bioinsumos JCO, pois prospectará novas cepas e aprimorará os produtos existentes no catálogo, que possuem pilares de produção fundamentados no Programa Nacional de Bioinsumos (10.375/2020). Além disso, fortalece o acesso ao patrimônio genético do país, firmando o compromisso com a Lei da Biodiversidade (13.123/2015).
Fonte: Assessoria de comunicação da JCO Bioprodutos
Contato: marketingjco@jcobioprodutos.com.br
Referências
BRASIL. Lei nº 13.123, de 20 de maio de 2015. Dispõe sobre o acesso ao patrimônio genético, sobre a proteção e o acesso ao conhecimento tradicional associado e sobre a repartição de benefícios para conservação e uso sustentável da biodiversidade. Diário Oficial da União: seção 1, Brasília, DF, 21 maio 2015. Disponível em: https://www.planalto.gov.br/ccivil_03/_ato2015-2018/2015/lei/l13123.htm. Acesso em: 17 jun. 2025.
BRASIL. Decreto nº 10.375, de 26 de maio de 2020. Institui o Programa Nacional de Bioinsumos e o Conselho Estratégico do Programa Nacional de Bioinsumos. Diário Oficial da União: seção 1, Brasília DF, ano 158, n. 99, p. 105, 27 maio 2020. Disponível em: https://www.planalto.gov.br/ccivil_03/_Ato2019-2022/2020/Decreto/D10375.htm. Acesso em: 17 jun. 2025.
BRASIL. Sistema de Informação sobre a Biodiversidade Brasileira – SiBBr. Coleção Biológica Rosa de Oliveira – CBRO. Disponível em: https://collectory.sibbr.gov.br/collectory/public/show/co775. Acesso em: 17 jun. 2025.
BRASIL. Ministério da Ciência, Tecnologia e Inovação. Cadastro de coleções biológicas no SiBBr. Sistema de Informação sobre a Biodiversidade Brasileira – SiBBr. Disponível em: https://sibbr.gov.br/page/cadastro-colecoes.html?lang=pt_BR. Acesso em: 17 jun. 2025.